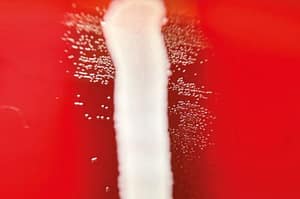
Evaluación de la susceptibilidad directa desde hemocultivos positivos utilizando el sistema Vitek 2: comparación de dos protocolos rápidos

Evaluación de la susceptibilidad directa desde hemocultivos positivos utilizando el sistema Vitek 2: comparación de dos protocolos rápidos
Se comparó el ensayo de susceptibilidad a los antimicrobianos utilizando las tarjetas Vitek® 2 (bioMérieux) inoculadas directamente de hemocultivos positivos con el método estándar para bacilos gramnegativos. Se evaluaron dos protocolos diferentes para la preparación del inóculo. El segundo protocolo fue más rápido y fácil de realizar. Las pruebas de susceptibilidad rápida fueron precisas y redujeron el tiempo de los resultados en 24 h.
Lorena Porte, Francesca Gattini, Carmen Varela y Thomas Weitzel
Laboratorio Clínico, Clínica Alemana de Santiago.
Facultad de Medicina Clínica Alemana/Universidad del Desarrollo.
Correspondencia a: Lorena Porte T
lporte@alemana.cl
Rev. chil. infectol. vol.34 no.2 Santiago abr. 2017
http://dx.doi.org/10.4067/S0716-10182017000200014
Bernanda Morín #488, 2° Piso, Providencia, Santiago, Chile. Fono/Fax: (56-2) 23413539 revinf@sochinf.cl
Antimicrobial susceptibility testing using Vitek® 2 (bioMérieux) cards inoculated directly from positive blood cultures was compared with the standard method for gramnegative rods. Two different protocols for the inoculum preparation were evaluated. Protocol 2 was faster and easier to perform. Rapid susceptibility testing was accurate and reduced time to results in 24 h.
Keywords: Microbial sensitivity tests, blood culture, gram-negative bacteria.
Resumen
Se comparó el ensayo de susceptibilidad a los antimicrobianos utilizando las tarjetas Vitek® 2 (bioMérieux) inoculadas directamente de hemocultivos positivos con el método estándar para bacilos gramnegativos. Se evaluaron dos protocolos diferentes para la preparación del inóculo. El segundo protocolo fue más rápido y fácil de realizar. Las pruebas de susceptibilidad rápida fueron precisas y redujeron el tiempo de los resultados en 24 h.
Palabras clave: Pruebas de sensibilidad microbiana, hemocultivos, bacilos gramnegativos.
El inicio precoz de la terapia antimicrobiana adecuada, reduce la morbimortalidad asociada a la sepsis. Sin embargo, los estudios de susceptibilidad generalmente requieren 48 h desde que se detecta desarrollo bacteriano en un hemocultivo. La literatura especializada indica que en el caso de los bacilos gramnegativos, es posible obtener la susceptibilidad antimicrobiana 24 h antes si ésta se realiza directamente a partir de hemocultivos positivos, sin necesidad de esperar el desarrollo bacteriano en cultivo sólido1,2. Nuestro objetivo fue evaluar esta metodología utilizando dos protocolos distintos de siembra directa y compararlos con el método tradicional (a partir de una cepa pura).
Método: Entre abril y junio de 2015, se incluyeron hemocultivos positivos (BacT/Alert FA plus®, bioMérieux) consecutivos con desarrollo de bacilos gramnegativos, incubados en el equipo BacT/Alert® (bioMérieux). Se excluyeron las muestras duplicadas. Se aplicaron dos protocolos de siembra directa de las tarjetas de susceptibilidad Vitek® 2 (Figura 1). El protocolo 1 consistió en inocular 5 mL de sangre de un hemocultivo positivo en un tubo sin aditivos y centrifugar a 600 x g por 10 min. Luego, transferir el sobrenadante a otro tubo y centrifugar a 3.000 x g por 10 min para crear un pellet de bacterias, resuspenderlo en 2 mL de solución salina 0,45% y ajustarlo a McFarland 0,5-0,631. En el protocolo 2, se inocularon 5 mL de sangre de un hemocultivo positivo en un tubo con gel separador (BD Vacutainer, Rutherford, NJ, USA), el que fue centrifugado a 2.000 x g por 10 min. Se eliminó el sobrenadante y se removió el sedimento en la superficie de gel con una tórula, para resuspenderlo en 2 mL de solución salina 0,45% y ajustarlo a McFarland 0,5-0,633.

Las suspensiones obtenidas mediante ambos protocolos fueron cargadas en las tarjetas Vitek 2 AST 249, según instrucciones del fabricante. En paralelo, cada botella fue subcultivada en medios sólidos según procedimiento de rutina para identificación (Vitek® MS, bioMérieux) y susceptibilidad antimicrobiana (Vitek® 2). Los antimicrobianos evaluados fueron amikacina (AKA), cefazolina (CFZ), cefepime (CEF), cefotaxima (CTX), ceftazidima (CAZ), cefuroximo (CXM), ciprofloxacina (CIP), ertapenem (ERT), gentamicina (GEN), imipenem (IMI), meropenem (MEM), piperacilina/tazobactam (PTZ) y cotrimoxazol (SXT).
La concordancia e interpretación fueron analizadas según las normas CUMITECH 31A para verificaciones en que no se compara contra un método estándar4:
a. < 5% de errores mayores (EMA): Susceptibilidad rápida indica resistente (R) y tradicional sensible (S).
b. > 90% de concordancia categórica (S, I, R) y esencial (CIM ± 1 dilución).
c. < 10% suma de EMA y errores menores (EME): Susceptibilidad rápida o tradicional indican susceptibilidad intermedia (I).
Hubo desarrollo de 61 bacilos gramnegativos: 40 E. coli, 14 otras enterobacterias (6 Klebsiella spp., 4 Enterobacter spp., 2 Proteus spp., 2 salmonella sp.). Ambos protocolos de extracción produjeron los mismos resultados, sin embargo, el protocolo 2 resultó más rápido y fácil. Diez cepas fueron R a cefotaxima. Hubo tres enterobacterias R a ertapenem, dos R y una I a imipenem y una R y dos I a meropenem. Las concordancias categórica y esencial entre ambos métodos de susceptibilidad antimicrobiana fueron de 99,7% y 99,2% respectivamente. El porcentaje de EMA fue < 5% y la combinación de EMA y EME fue < 10% en todos los antimicrobianos (Tabla 1).

La principal limitación de este estudio es el escaso número de aislados incluidos, por lo que los resultados deben interpretarse como preliminares y requieren confirmación con un mayor número de cepas. Sin embargo, esta metodología abre la posibilidad de contar con un resultado de susceptibilidad 24 h antes que lo habitual, resultando muy útil en caso de pacientes graves que requieren el inicio precoz del antimicrobiano más adecuado.
Referencias Bibliográficas
1.- Gherardi G, Angeletti S, Panitti M, Pompilio A, Di Bonaventura G, Crea F, et al. Comparative evaluation of the Vitek-2 Compact and Phoenix systems for rapid identification and antibiotic susceptibility testing directly from blood cultures of Gram-negative and Gram-positive isolates. Diagn Microbiol Infect Dis 2012; 72: 20-31.
2.- Hazelton B, Thomas L C, Olma T, Kok J, O’Sullivan M, Chen S C, et al. Rapid and accurate direct antibiotic susceptibility testing of blood culture broths using MALDI Sepsityper combined with the BD Phoenix automated system. J Med Microbiol 2014; 63: 1590-4.
3.- Kerremans J, Goessens W H, Verbrugh H A, Vos M C. Accuracy of identification and susceptibility results by direct inoculation of Vitek 2 cards from positive BACTEC cultures. Eur J Clin Microbiol Infect Dis 2004; 23: 892-8.
4.- Clark R B, Lewinsky M A, Loeffelholz M J, Tibbetts. 2009. Cumitech 31A, verification and validation of procedures in the clinical microbiology laboratory. Coordinating ed., S. E. Sharp. ASM Press, Washington, DC.




